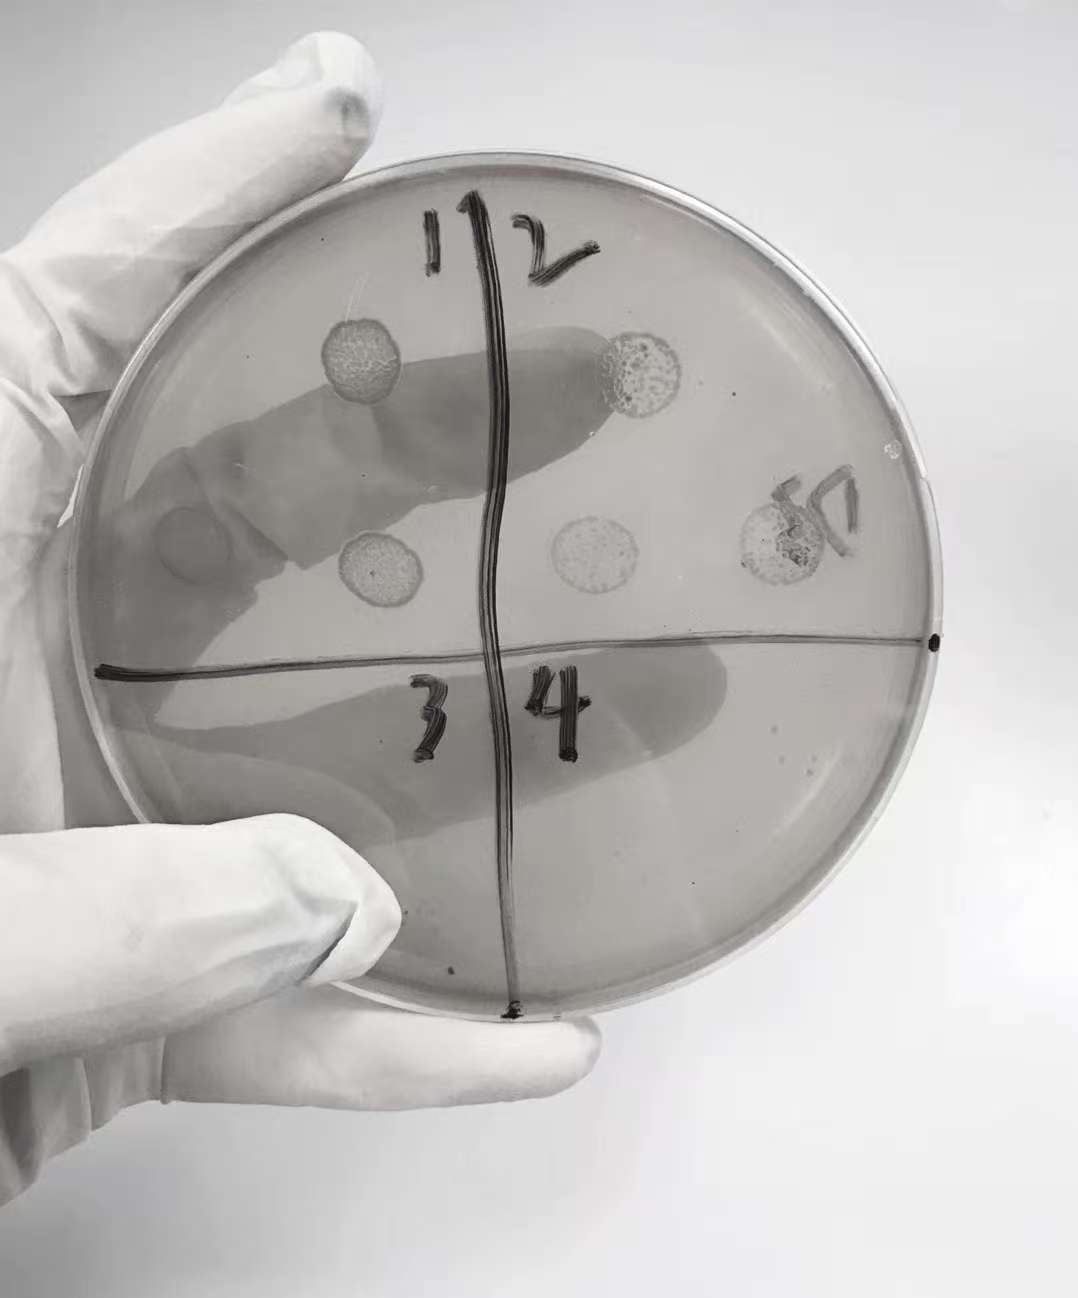
【大国粮策】喝凉水都长胖？减肥的秘密，竟然藏在肠道里

点击右上角
微信好友
朋友圈

请使用浏览器分享功能进行分享

山西农业大学山西功能食品研究院副研究员刘双的抽屉里,藏着两件特别的“宝贝”:一件是用了五年的血糖测试仪,另一件,是记录着187种食材餐后血糖数据的笔记本,从食材品种到加工方式的影响,都清晰地记录其中。


血糖测试仪和笔记本
这两件物品代表了刘双的工作领域——过去她研究舌尖上的美味,如今则在揭秘粪便里的健康真相。
没错,这里所说的正是人们日常认知中的“粪便”。或许有人会好奇,一位研究食品的科研人员,怎么会专注于粪便样本研究?一组数据或许能解释这一跨界研究的意义:全球每5秒钟,就有1个人死于糖尿病并发症;在我国,糖尿病患者已超过1.4亿,其中90%属于2型糖尿病。而与糖尿病相关的肥胖、心血管等慢性病,已占到全球死亡总人数的70%。

糖尿病等慢性代谢疾病数据
这些疾病的秘密,很可能就藏在我们的肠道中。人们吃进嘴里的每一口食物,进入肠道后都会成为数百亿微生物的“口粮”——这群看不见的“小伙伴”组成的肠道菌群,与代谢病的发生有着密切关联。
刘双团队曾发现一种名为阴沟肠杆菌B29的细菌。起初,这种细菌并未引起特别关注,直到研究发现它在一位340斤的肥胖患者肠道内占比高达30%。研究人员将其分离出来,植入无菌小鼠体内后,食用高脂饲料的小鼠很快出现肥胖问题,同时伴随血糖、血脂异常。
进一步研究揭示,B29会分泌内毒素引发全身炎症,破坏胰岛素受体,导致胰岛素抵抗;它还会分泌吲哚和硫化氢,这两种物质能抑制肠道分泌饱腹感激素,使人越吃越饿,病情也随之加重。这一发现印证了“慢性病肠源性学说”——许多慢性病的源头可能始于肠道。
肠道细菌分离
那么,什么样的肠道菌群才算健康?实际上,肠道菌群中有两大“阵营”:“基石功能群”是守护健康的主力军,负责消化吸收、免疫调节与代谢平衡;“病生功能群”平时属于“中立派”,能帮助训练免疫系统,但一旦数量超标就会“兴风作浪”。两者如同跷跷板,健康人体内“基石功能群”占据优势,而生病时则会呈现相反的态势。
刘双团队找到了调节菌群的方法——通过给菌群“换食谱”,让其结构更合理。
为了绘制这样一张健康食谱,刘双和团队成员化身行走的“餐后血糖测评仪”,测试过的食材遍布全国:从东北黑土地的大米,到黄土高原的燕麦,再到彩云之南的鸡枞菌……听起来像一场美食之旅,但实际过程却充满挑战。
为保证检测结果准确,他们食用的都是无调料的原味食物;为模拟最大进食量下的真实血糖情况,还不能少吃;甚至要直接品尝葫芦巴碱、苦瓜皂苷制成的粉剂,“吃吐”是常有的事,因此大家笑称他们是“现代版神农尝百草”。
频繁扎针更是家常便饭。实验最密集时,刘双曾连续45天每天扎5次手指测血糖,十个手指头布满针眼,连敲键盘都感到疼痛。

细胞培养工作
但这份辛苦换来了丰硕的成果。研究发现,不同加工和烹饪方式对血糖的影响天差地别:同样是红薯,蒸后放冷食用能控糖,煮着吃却成了“血糖刺客”;看似健康的全麦粉,做成冲调粉时升糖很快,压成死面窝头才是控糖能手——加工方式的重要性由此可见一斑。
基于这些实验,团队筛选出不升糖的原料,研究合适的加工方式以避免其被快速消化,再通过动物和人体实验,最终研发出能精准调节肠道基石功能群的食品。

功能食品加工现场作业
他们研发的高膳食纤维食品,让那位340斤的肥胖患者食用半年后,肠道菌群结构显著改善,体重成功减轻170多斤;部分2型糖尿病患者食用12周后,肠道内被誉为“健康小助手”的短链脂肪酸产生菌数量增多,血糖血脂均下降,这项研究还登上了《Science》杂志;为多囊卵巢综合征患者研发的干预食品,有效改善了她们的症状,有些姑娘甚至已顺利成为妈妈。
如今,团队已摸清“基石功能群”的“胃口”——它们不喜欢能快速消化释放能量的米饭、馒头,更偏爱富含膳食纤维、可缓慢发酵的复杂碳水化合物。为响应国家倡导的体重管理3年计划,他们打算从人们每日食用的主食入手,掀起一场“主食变革”:农业提供优质原料,菌群需求指明方向,食品技术充当引擎,而每个人都能参与其中,让疾病预防与健康维护变得更科学、高效。
回望这段科研之路,其中的辛苦不言而喻。刘双身边也总有人好奇,天天与粪便样本打交道,难道不觉得气味“上头”吗?

人体粪便样品库
刘双坦言,刚开始研究肠道菌群时,即便隔着口罩,刺鼻的气味也曾让她怀疑人生。但神奇的是,在与样本朝夕相处的三个月里,她竟练就了“闭气取样、屏息操作”的本事。原来人类的适应力,远比想象中更强大。而最让她感动的,还是看到患者食用团队研发的食品后指标好转的那一刻,所有疲惫都瞬间烟消云散,那种兴奋与满足难以用言语形容。
科研的每一次突破,都像打开了新世界的大门。刘双常想,他们的研究如今只是广袤健康谜题中的一小块拼图,但正是无数科研工作者的点滴积累,才能在未来勾勒出全民健康的美好画面。
作者:刘双 山西农业大学山西功能食品研究院副研究员
策划统筹:宋雅娟 武玥彤
编辑整理:李欣哲

